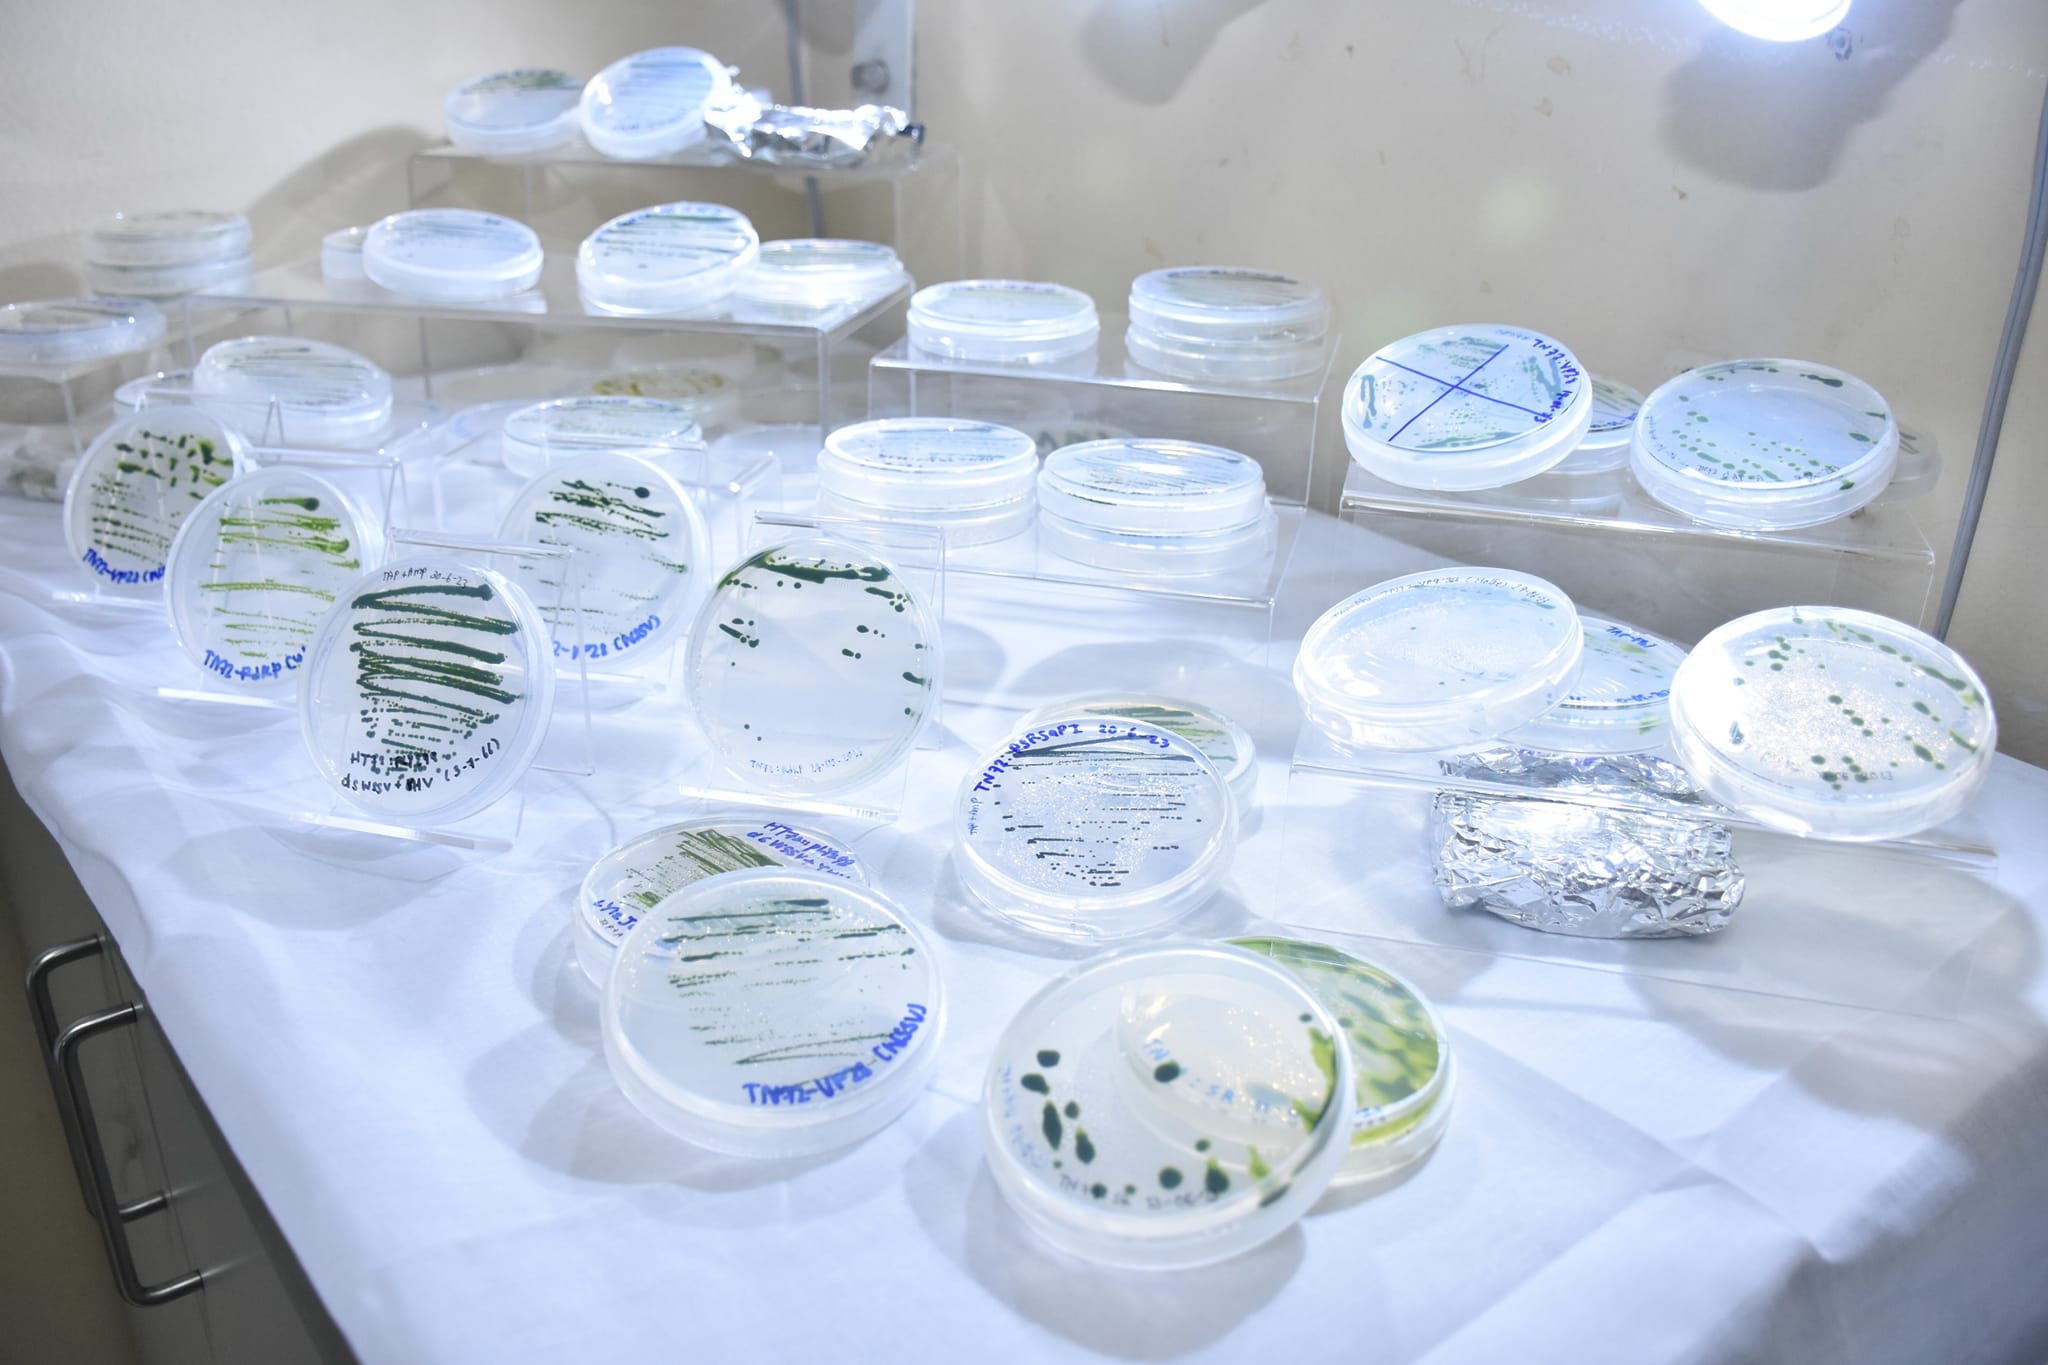

Last updated: 17 ก.ค. 2566 | 923 จำนวนผู้เข้าชม |
"ไบโอเทค-สวทช." โชว์งานวิจัยด้านสาหร่ายกว่า 20 ปี สร้างจุดแข็งอุตสาหกรรมเพาะเลี้ยงสัตว์น้ำไทย หวังกลับมาเป็นผู้ส่งออกสัตว์น้ำแถวหน้าของโลกได้อีกครั้ง
อุตสาหกรรมการเพาะเลี้ยงกุ้งในประเทศทำเงินสร้างรายได้เข้าประเทศปีละหลายล้านบาท แม้ว่าประเทศไทยเป็นเคยเป็นผู้นำในด้านการส่งออกกุ้งของโลกแต่ปัจจุบันไม่ได้เป็นผู้นำเนื่องจากมีเกษตรกรผู้เลี้ยงกุ้งจำนวนมากประสบปัญหาโรคในกุ้งและสัตว์น้ำอื่นๆ
ศูนย์พันธุวิศวกรรมและเทคโนโลยีชีวภาพแห่งชาติ (ไบโอเทค) สำนักงานพัฒนาวิทยาศาสตร์และเทคโนโลยีแห่งชาติ (สวทช.) ดำเนินงานวิจัยและพัฒนาเทคโนโลยีชีวภาพด้านสาหร่ายมาอย่างต่อเนื่องมากกว่า 20 ปี มีหน่วยวิจัยเฉพาะด้าน ได้แก่ ทีมวิจัยเทคโนโลยีชีวภาพปลาและกุ้ง ซึ่งร่วมกับคณะวิทยาศาสตร์ มหาวิทยาลัยมหิดล พัฒนาการนำส่งสาหร่ายเซลล์เดียวดัดแปลงทางการกินช่วยแก้ไขปัญหาโรคในกุ้งและสัตว์น้ำอื่น และทีมวิจัยชีวศาสตร์และชีววิทยาระบบ ซึ่งร่วมกับมหาวิทยาลัยเทคโนโลยีพระจอมเกล้าธนบุรี พัฒนาชีววิทยาระบบของสาหร่ายครบวงจร ตั้งแต่ต้นน้ำถึงปลายน้ำ ทั้งการเพาะเลี้ยง การสกัดสารสำคัญ และการเพิ่มมูลค่า ทั้งหมดล้วนเพื่อช่วยสนับสนุนอุตสาหกรรมการเพาะเลี้ยงสัตว์น้ำ (Aquaculture) ให้เกิดความยั่งยืน ลดพึ่งพาเทคโนโลยีต่างประเทศ สร้างจุดแข็งการเพาะเลี้ยงสัตว์น้ำไทย หวังกลับมาเป็นผู้ส่งออกสัตว์น้ำแถวหน้าของโลกได้อีกครั้ง

ทีมวิจัยเทคโนโลยีชีวภาพปลาและกุ้ง ไบโอเทค สวทช. ที่มีความร่วมมือกับคณะวิทยาศาสตร์ ม.มหิดล
ดร.วรรณวิมล ศักดิ์เสมอพรหม หัวหน้าทีมวิจัยเทคโนโลยีชีวภาพปลาและกุ้ง ไบโอเทค สวทช. เปิดเผยว่า ตลอดระยะเวลา 20 ปีที่ผ่านมา ม.มหิดล และไบโอเทค สวทช. ได้ร่วมกันสร้างองค์ความรู้ทางวิทยาศาสตร์ด้านเทคโนโลยีชีวภาพเพื่อนำไปสู่การแก้ปัญหาและส่งเสริมการเพาะเลี้ยงสัตว์น้ำอย่างต่อเนื่อง โดยเฉพาะการเพาะเลี้ยงกุ้งเศรษฐกิจ เกิดเป็น “หน่วยวิจัยเพื่อความเป็นเลิศเทคโนโลยีชีวภาพกุ้ง (Centex Shrimp)” เพื่อพัฒนางานวิจัยที่เกี่ยวกับเรื่องโรคกุ้งและโรคในสัตว์น้ำชนิดอื่น
โดยงานวิจัยด้านสาหร่ายที่พัฒนาคือ เทคโนโลยีชีวภาพของสาหร่ายเซลล์เดียว ที่มีการดัดแปลงพันธุกรรมของสาหร่ายเซลล์เดียวให้สามารถสร้างชีวโมเลกุลอื่น ๆ ที่มีฤทธิ์ต้านโรคอย่างมีประสิทธิภาพและจำเพาะเจาะจง รวมถึงมีคุณลักษณะในการสังเคราะห์อาหารด้วยแสงเป็นตัวคัดเลือกสาหร่ายที่ได้รับการดัดแปลง แทนที่จะใช้ยีนต้านยาปฏิชีวนะอย่างในระบบการดัดแปลงพันธุกรรมดั้งเดิมที่ใช้กันซึ่งสร้างความกังวลแก่การนำไปใช้จริง โดยสาหร่ายเซลล์เดียวนี้ทำให้การใช้จุลชีพดัดแปลงในอุตสาหกรรมเลี้ยงกุ้งมีความเป็นไปได้มากขึ้น เนื่องจากการระบาดของโรคไวรัสยังเกิดขึ้นต่อเนื่องและยังไม่มีเทคโนโลยีชีวภาพใดช่วยได้อย่างมีประสิทธิภาพในระดับฟาร์ม โดยสารชีวโมเลกุลที่ทีมได้วิจัยขึ้นพิสูจน์แล้วว่า มีประสิทธิภาพสูงในการยับยั้งโรคไวรัส ได้แก่ อาร์เอ็นสายคู่ที่จำเพาะต่อสารพันธุกรรมของไวรัส ซึ่งจะยับยั้งการเพิ่มจำนวนของไวรัสผ่านกระบวนการอาร์เอ็นเออินเตอร์เฟียแรนซ์ สามารถนำส่งสาหร่ายเซลล์เดียวดัดแปลงทางการกิน ทำให้เกิดความสะดวกในการนำส่งอาร์เอ็นเอสายคู่ ลดขั้นตอนทำบริสุทธิ์ และยังทำให้สัตว์น้ำได้รับสารอาหารเพิ่มเติมจากสารชีวโมเลกุลที่มีอยู่แล้วด้วย จากผลวิจัย พบว่า สามารถป้องกันการตายจากโรคตัวแดงดวงขาวได้ถึง 70% เมื่อเทียบกับกลุ่มควบคุมและกลุ่มที่ได้กินสาหร่ายสายพันธุ์ดั้งเดิมที่อัตราตายเกือบ 100% นับเป็นช่วงเวลาสำคัญที่จะช่วยซื้อเวลาให้กับเกษตรกรในการกอบกู้สถานการณ์ แก้ไขปัญหาหน้าฟาร์ม เพื่อลดความรุนแรงของโรคไวรัส เพิ่มภูมิคุ้มกัน และเพิ่มการเติบโต ลดความสูญเสียที่จะเกิดขึ้น

“เทคโนโลยีชีวภาพของสาหร่ายเซลล์เดียว ไม่ได้จำกัดเพียงแค่การใช้เพื่อผลิตอาร์เอ็นเอสายคู่ แต่ยังขยายผลใช้ผลิตสารชีวโมเลกุลชนิดอื่น ๆ ได้ เช่น โปรตีนเพื่อพัฒนาเป็นซับยูนิตวัคซีนแบบกิน โปรตีนที่ช่วยเพิ่มการเติบโตของสัตว์น้ำ และเปบไทด์สายสั้นที่ได้พิสูจน์แล้วว่ามีฤทธิ์ทางชีวภาพ เพื่อเป็นอาหารเสริมฟังก์ชั่นให้แก่สัตว์น้ำ โดยนอกจากผงสาหร่ายเซลล์เดียวดัดแปลงที่พัฒนาขึ้น ทีมวิจัยยังมีระบบการผลิตสารชีวโมเลกุลที่พร้อมให้ประยุกต์ใช้เพื่อผลิตสารชีวโมเลกุลตามโจทย์ความต้องการเกษตรกรในด้านต่าง ๆ เพื่อเพิ่มมูลค่าให้กับผลิตภัณฑ์สัตว์น้ำในประเทศไทยและศักยภาพในการแข่งขันกับตลาดโลก โดยในการดำเนินงานวิจัยและพัฒนาของทีมวิจัยได้สร้างผลกระทบในหลายภาคส่วน ทั้งในด้านเศรษฐกิจที่มีการนำผลงานวิจัยและองค์ความรู้ไปใช้ในอุตสาหกรรมการเพาะเลี้ยง และมีเอกชนด้านอาหารและเวชภัณฑ์นำไปต่อยอดเชิงพาณิชย์เพื่อสร้างมูลค่าเพิ่ม ลดการพึ่งพาเทคโนโลยีจากต่างประเทศ ในด้านสังคมเกิดการนำผลงานไปใช้ประโยชน์ในกลุ่มเกษตรผู้เพาะเลี้ยง และในด้านวิชาการมีการต่อยอดผลงานวิจัยจากนักวิจัยทั้งในและต่างประเทศ มีจำนวนอ้างอิงผลงานเพิ่มขึ้นอย่างต่อเนื่อง ทั้งนี้ ทีมวิจัยหวังว่า วันหนึ่งในอนาคตอันใกล้นี้ เทคโนโลยีชีวภาพของสาหร่ายเซลล์เดียวจะเป็นกลไกหนึ่งที่มีส่วนช่วยเพิ่มประสิทธิภาพในการจัดการฟาร์ม ส่งผลให้คุณภาพชีวิตของเกษตรกรดีขึ้น ส่งผลให้ประเทศไทยกลับมาเป็นผู้นำการส่งออกสัตว์น้ำได้อีกครั้ง” ดร.วรรณวิมล กล่าว

ทีมวิจัยชีวศาสตร์และชีววิทยาระบบ ไบโอเทค สวทช. ที่มีความร่วมมือกับ มจธ.
ดร.อภิรดี หงส์ทอง หัวหน้าทีมวิจัยชีวศาสตร์และชีววิทยาระบบ ไบโอเทค สวทช. เปิดเผยว่า ความร่วมมือระหว่าง ไบโอเทค สวทช. กับ ม.เทคโนโลยีพระจอมเกล้าธนบุรี เริ่มมาตั้งแต่ปี 2530 ด้วยโครงการ “การนำน้ำทิ้งจากโรงงานแป้งมันสำปะหลังมาเป็นแหล่งอาหารเพื่อใช้เลี้ยงสาหร่ายสไปรูลิน่า” เกิดเป็นการจัดตั้ง “กลุ่มวิจัยเทคโนโลยีชีวภาพสาหร่าย (Algal Biotechnology)” ที่ดำเนินงานโดยทีมอาจารย์นักวิจัย มจธ. และนักวิจัยไบโอเทค โดยงานวิจัยและพัฒนาของกลุ่มวิจัย เน้น 3 แนวทางหลัก ได้แก่
1) การเพาะเลี้ยง (Mass Cultivation) มุ่งเน้นให้ได้ผลผลิตและประโยชน์จากผลผลิตมากที่สุด มีงานวิจัยถึงผลของปัจจัยสิ่งแวดล้อมต่อการเจริญของสาหร่ายสไปรูลิน่า การพัฒนาและคัดเลือกสายพันธุ์ การพัฒนาสูตรอาหาร และการศึกษาด้านการจำลองทางคณิตศาสตร์ของระบบเพาะเลี้ยง โดยได้พัฒนาระบบการเพาะเลี้ยง ตั้งแต่ห้องแล็บจนระดับอุตสาหกรรม บ่อระบบเพาะเลี้ยงนอกอาคาร ซึ่งการศึกษาเริ่มที่สไปรูลิน่า รวมไปถึงสาหร่ายขนาดเล็กอื่นๆ และยังเป็นศูนย์ฝึกอบรมระบบการเพาะเลี้ยงแก่ภาคเอกชนและฟาร์มที่จะเลี้ยงสาหร่ายด้วย

2) สารเคมีมูลค่าสูง (High Value Chemicals) โดยศึกษาวิจัยสภาวะการเลี้ยง อิทธิพลของปัจจัยแวดล้อมต่อการสร้างสารต่าง ๆ ในสไปรูลิน่า การสกัดสารเคมีมูลค่าสูง เช่น ลิปิด กรดไขมันโอเมก้า3 ไฟโคไซยานิน และโพลีแซคคาไรด์จากสไปรูลิน่า รวมถึงศึกษาคุณสมบัติการเป็นสารออกฤทธิ์ชีวภาพ (Bioactive compound) ของสารต่าง ๆ ในสไปรูลิน่า งานด้านนี้จะเน้นเรื่องการสกัดสารสำคัญจากสาหร่ายสไปรูลิน่า เช่น ไฟโคไซยานินที่เป็นสารสีน้ำเงิน ซึ่งมีมูลค่าทางเศรษฐกิจสูงถึงกิโลกรัมละ 14,000 บาท และมีบทความวิจัยที่แสดงการนำไปใช้ในทางการแพทย์เกี่ยวกับโรคอัลไซเมอร์ด้วย โดยกลุ่มวิจัยศึกษาถึงกระบวนการสกัดและขยายการผลิตให้มีต้นทุนต่ำลง
3) การศึกษาด้านชีวโมเลกุล (Molecular biology) มุ่งเน้นให้เกิดความรู้ความเข้าใจระดับชีวโมเลกุลของสาหร่ายสไปรูลิน่า รวมถึงกลไกการควบคุม และการสังเคราะห์สารออกฤทธิ์ชีวภาพ (Bioactive compound) โดยเป็นการศึกษาระดับเซลล์ เช่น สภาวะ stress response (การตอบสนองต่อความเครียดของเซลล์) ช่วงเวลาและปัจจัยการเลี้ยงที่มีผลต่อการสร้างสารเป้าหมาย เป็นต้น ซึ่งล้วนมีผลต่อการสร้างสารสำคัญของสาหร่าย นอกจากนั้นมีการพัฒนาระบบการถ่ายทอดยีนเข้าไปในสาหร่ายสไปรูลิน่า เพื่อใช้เป็นแหล่งผลิตสารเป้าหมาย รวมถึงวิจัยต่อยอดในเรื่องการสกัดโปรตีนจากสาหร่าย เพื่อผลิตเปปไทด์ออกฤทธิ์ต้านทานเชื้อโรค ใช้เป็นอาหารเสริมให้ลูกกุ้งขาววัยอ่อน และใช้สาหร่ายเป็นแหล่งโปรตีนทางเลือกด้วย

“กลุ่มวิจัยเทคโนโลยีชีวภาพสาหร่าย มีองค์ความรู้ (knowledge) และความชำนาญ (know-how) ในเรื่องชีววิทยาระบบ (system biology) เป็นอย่างดี งานวิจัยครบวงจร ตั้งแต่การเพาะเลี้ยง การสกัดหรือดึงสารสำคัญของสาหร่ายออกมาใช้ประโยชน์ และการเพิ่มมูลค่าโดยเฉพาะต่อยอดให้เกิดเป็นเปปไทด์ออกฤทธิ์ทางชีวภาพ (Bioactive peptide) ต่าง ๆ รวมทั้งวิเคราะห์ Bioactive peptide ชนิดต่าง ๆ ด้วย AI-based Platform ชื่อ SmartBioPep ที่ทางกลุ่มวิจัยได้พัฒนาขึ้นเอง ซึ่งการดำเนินงานใน 3 แนวทางข้างต้นสามารถนำไปปรับใช้กับการศึกษาในสิ่งมีชีวิตอื่น ๆ ที่ไม่ใช่แค่เพียงสาหร่ายสไปรูลิน่าได้ด้วย ซึ่งที่ผ่านมาทางกลุ่มวิจัยได้มีการทำงานร่วมกับภาคเอกชนที่เป็นบริษัทชั้นนำของประเทศในการศึกษาวิจัยเชิงลึก มีการถ่ายทอดเทคโนโลยีการเพาะเลี้ยง และการออกแบบระบบ รวมถึงกระบวนการสกัดสารเคมีมูลค่าสูงจากสาหร่ายสไปรูลิน่าให้แก่ภาคเอกชนที่เป็นกลุ่มอุตสาหกรรมเกี่ยวกับเทคโนโลยีชีวภาพสาหร่าย ทั้งนี้ เพื่อผลักดันให้เกิดเป็นเครือข่ายระหว่างกัน แลกเปลี่ยนข้อมูลทางวิชาการ อันจะนำไปสู่การให้คำปรึกษาและแก้ไขปัญหาเพื่อเพิ่มประสิทธิภาพการผลิตของภาคอุตสาหกรรม และผลิตงานวิจัยได้ตรงความต้องการของภาคอุตสาหกรรม ตลอดจนพัฒนาสู่ความเป็นเลิศทางเทคโนโลยีชีวภาพสาหร่ายของกลุ่มวิจัยต่อไป” ดร.อภิรดี กล่าว